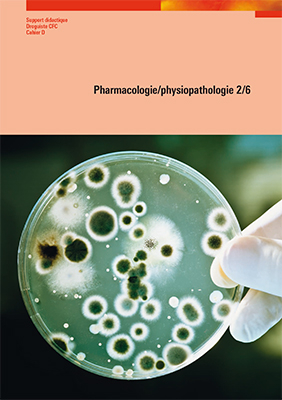
Pharmacologie/physiopathologie 2/6

Software / Digital Media
2018
|
Auflage:
1
|
Verlag Careum
ISBN: 9783037879931
CHF 23,75 (inkl. MwSt)
- Versand in
10-14 Tagen